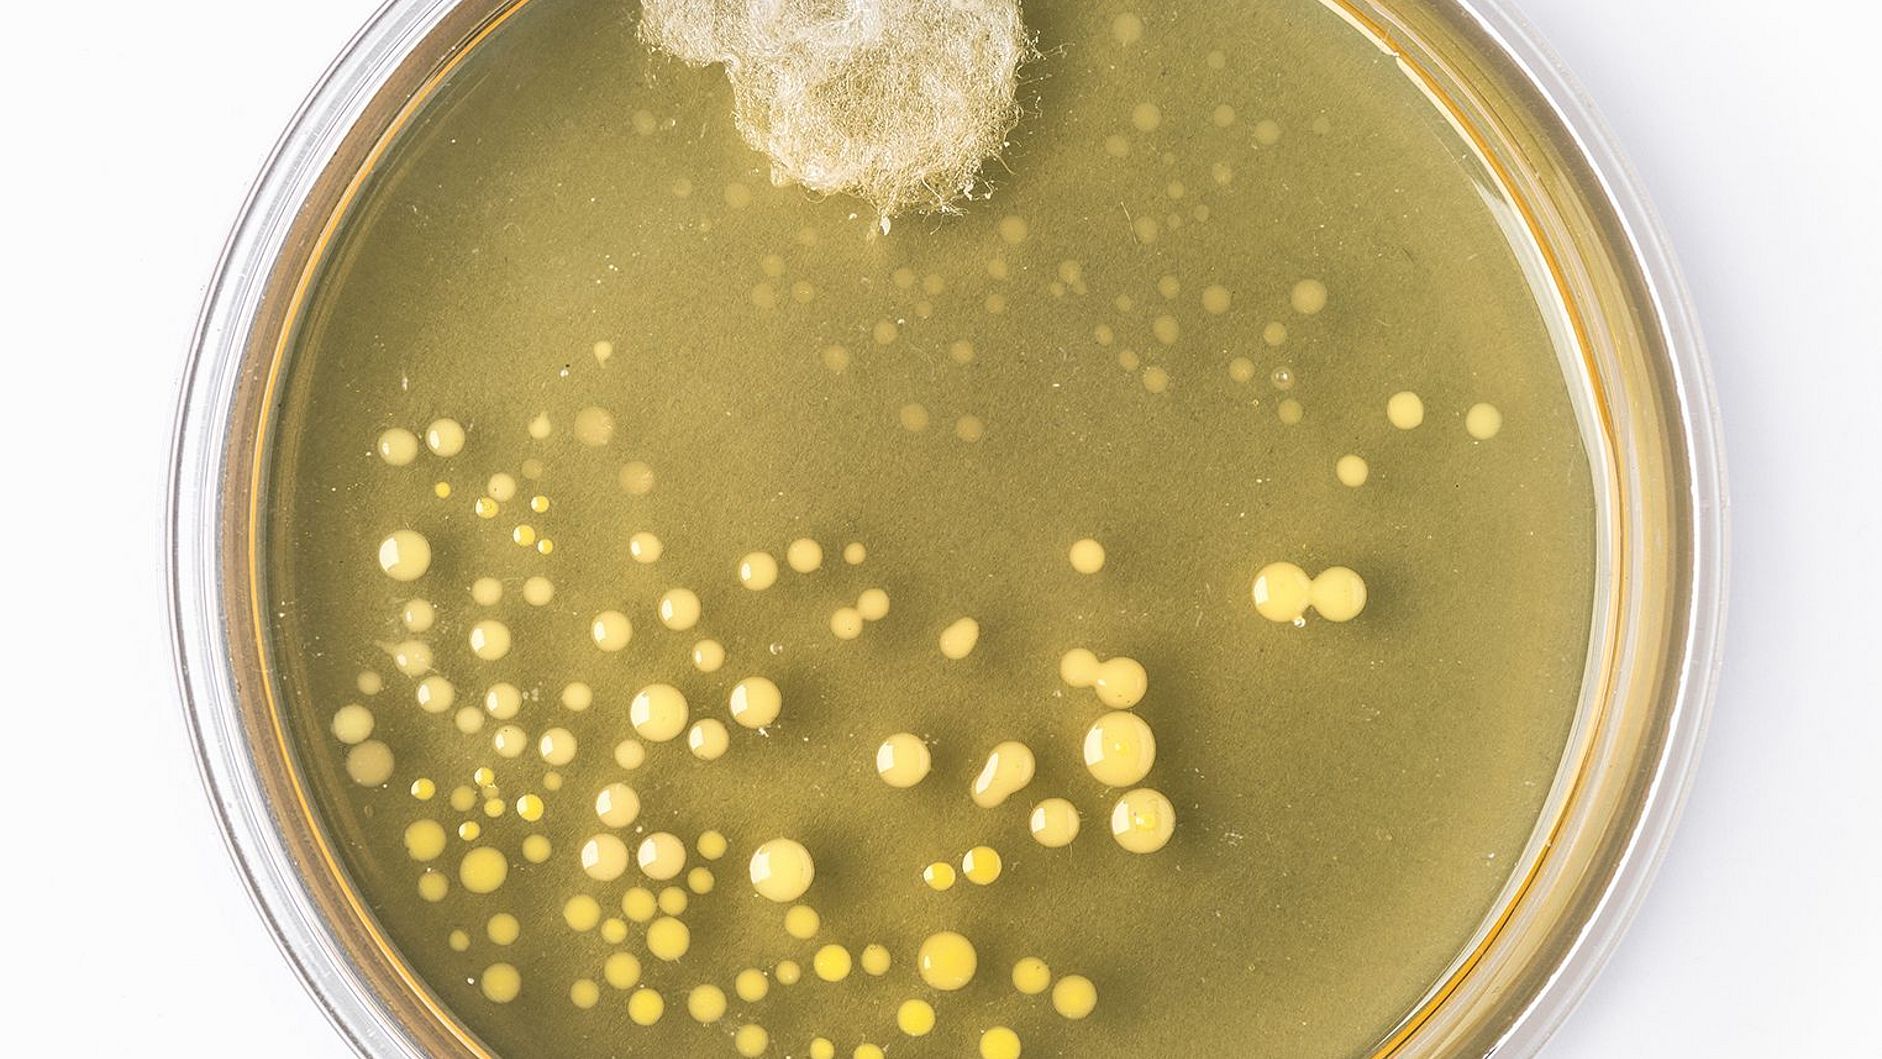
Nachbildung des berühmten Original-Petrischale von Alexander Fleming mit Schimmelpilz und Bakterienkolonien.

Seit Monaten nun schon prägen die Folgen der Corona-Pandemie unseren Alltag. Die einfache AHA-Regel fasst heutzutage kurz zusammen, wie man sich und andere schützen kann: Abstand halten, Hygiene beachten und Alltagsmaske (Mund-Nasen-Bedeckung).
Hygiene bedeutet hier, dass man in die Armbeuge husten und niesen, sich aber vor allem eben regelmäßig die Hände waschen soll. Also wenn man nach Hause kommt, nach dem Naseputzen, Niesen oder Husten, vor der Zubereitung von Speisen, vor dem Essen, nach dem Toilettengang, vor und nach dem Kontakt mit Erkrankten, vor dem Anlegen und nach dem Ablegen einer Mund-Nasen-Bedeckung.
Und wie wäscht man sich richtig die Hände? Am besten erst einmal die Hände nass machen, dann erst die Seife nehmen und die Hände rundum einseifen. Wichtig ist es, hier nicht nur die Handinnenfläche zu bearbeiten, sondern auch den Handrücken, die Fingerspitzen und die Fingerzwischenräume. Wie oben schon gesagt, kann es helfen hier »Happy Birthday« zu singen, um auf die erforderlichen 20 bis 30 Sekunden zu kommen. Dann die Hände sorgfältig abspülen und mit einem sauberen Handtuch gründlich abtrocknen.